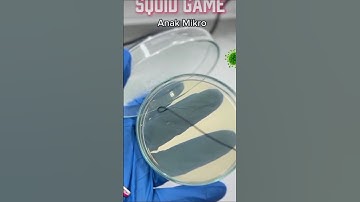
Anak mikro 🦠 #laboratory #science #laboratorytechniques #labtechnition #lab #microbiology #shorts

⬇ DOWNLOAD NOW
Kalau muncul iklan pop-up, tutup lalu klik tombol kembali
Download lagu Microbiology #laboratory #science #laboratorytechniques #lab #biotech #microbiology secara gratis hanya untuk keperluan promosi. Dukung artis favorit kamu dengan membeli musik original di iTunes atau platform resmi lainnya.
 Microbiology 🦠 #laboratory #science #laboratorytechniques #labtechnition #lab #microbiology #shorts
Microbiology 🦠 #laboratory #science #laboratorytechniques #labtechnition #lab #microbiology #shorts
 The Ultimate Microbiology Laboratory Experience
The Ultimate Microbiology Laboratory Experience
 #laboratory #science #labtechnition #laboratorytechniques #lab #science #microbiology
#laboratory #science #labtechnition #laboratorytechniques #lab #science #microbiology
 microbiology lab #microbiology #laboratorylife #lab #microscope #music
microbiology lab #microbiology #laboratorylife #lab #microscope #music
 Camp test #laboratory #science #laboratorytechniques #labtechnition #microbiology #lab #shortvideo
Camp test #laboratory #science #laboratorytechniques #labtechnition #microbiology #lab #shortvideo
 Microbiology Lab Technique | Unittas Multispeciality Hospital #labservices
Microbiology Lab Technique | Unittas Multispeciality Hospital #labservices
 microbiology 🧫 🦠#laboratory #science #scientificjourney #lab #microbiology #labtechnition #shorts
microbiology 🧫 🦠#laboratory #science #scientificjourney #lab #microbiology #labtechnition #shorts
Anak mikro 🦠 #laboratory #science #laboratorytechniques #labtechnition #lab #microbiology #shorts
Anak mikro 🦠 #laboratory #science #laboratorytechniques #labtechnition #lab #microbiology #shorts